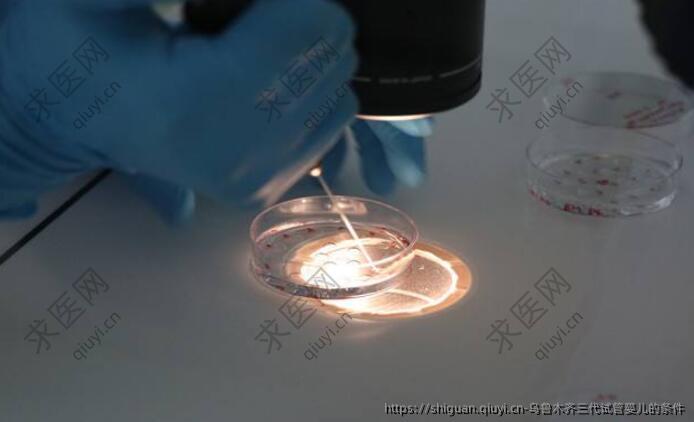

时间: 2025-04-10 11:30:17 62人阅读
三孕试管技术,即胚胎植入前遗传学诊断(PGD)和胚胎植入前遗传学筛查(PGS),是辅助生殖领域的一项重要进展。这项技术通过在胚胎移植前对胚胎进行遗传学检测,能够有效降低遗传疾病的风险,提高妊娠成功率。然而,在实际应用中,这项技术的使用受到严格限制,以下将从伦理、法律和技术层面分析三孕试管不允许做的条件。

首先,伦理层面是三孕试管技术应用的重要约束条件之一。在许多国家和地区,对于胚胎的选择和处理有严格的伦理规范。例如,不允许基于非医学需求选择**,这是为了防止性别歧视和社会失衡。此外,胚胎的筛选**以治疗遗传病为目的,而不是用于追求所谓的“设计婴儿”。这种限制旨在保护人类基因多样性和社会公平性,避免技术滥用导致伦理问题。
其次,法律框架也是三孕试管技术实施的重要依据。各国根据自身文化背景和社会价值观制定了相关法律法规。例如,在一些国家,只有当夫妻一方或双方携带明确遗传病风险时,才允许使用三孕试管技术。同时,法律通常规定**由具备资质的专业机构和人员操作,并要求患者提供充分知情同意书。这些法律条款确保了技术使用的合法性和安全性,同时也保护了患者的权益。
再次,技术条件本身也构成了三孕试管技术应用的限制因素。尽管三孕试管技术已经取得了显著进步,但其适用范围仍然有限。例如,对于某些复杂的遗传性疾病,当前的技术可能无法准确检测或干预。此外,胚胎活检过程中存在一定的风险,可能导致胚胎损伤或发育异常。因此,医生会综合评估患者的具体情况,权衡利弊后决定是否采用该技术。
另外,经济和社会资源分配也是影响三孕试管技术应用的重要因素。由于这项技术涉及较高的成本和复杂流程,很多地区将其纳入医疗保障体系时会设定严格的准入标准。例如,只有在其他常规治疗方法无效的情况下,才会考虑使用三孕试管技术。这种做法既是为了合理利用医疗资源,也是为了减轻患者经济负担。
最后,心理和社会适应性也是三孕试管技术使用中的考量因素。接受此类治疗的家庭需要面对较大的心理压力和不确定性,因此医疗机构通常会提供心理咨询和支持服务。同时,社会对遗传疾病的认知水平和接受度也会影响技术的应用范围。在推广三孕试管技术时,需要加强公众教育,提升社会整体认知水平。
三孕试管技术虽然为解决遗传疾病提供了新的可能性,但在实际应用中受到多方面限制。这些限制不仅来自伦理和法律层面,还涉及技术成熟度、经济可行性以及心理社会适应性等多个维度。未来,随着科学技术的进步和社会观念的变化,三孕试管技术的应用范围可能会逐步扩大,但仍需在科学与伦理之间找到平衡点,以实现技术的**化社会效益。
扩展阅读
您可能还会关注:
相关文章

2025-07-03 14:29:26

2025-07-15 12:59:56
2025-07-12 06:35:34

2025-08-02 06:16:49

2025-03-21 11:28:17

2025-04-10 20:39:53

2025-05-29 17:38:22
**问答
热门话题
#试管婴儿知识
#试管婴儿知识
试管婴儿技术是一种对医疗环境、设备要求都比较高的辅助生殖技术,试管婴儿技术主要有三种:一孕试管婴儿、二孕试管婴儿及三孕试管婴儿。一孕试管指的是常规的体外授精,二孕试管婴儿和三孕试管婴儿是在一孕试管婴儿技术的基础上多了一个单精子注射和基因检测的技术。
74417篇文章 · 17858篇问答
#三孕试管婴儿
#三孕试管婴儿
第三孕试管婴儿技术( PGD )是第一孕、第二孕基础上突破性的革新,也是试管婴儿技术上的一个里程牌, 它极大的改善了染色体有问题人群的生育问题,防止了遗传病的传递,选择健康囊胚移植,也大大提升了移植成功,第三孕技术就是从女性体内取出多个卵子, 在与精子结合发育成为胚胎到一定阶段后,用分子遗传的手段对其进行检测,存在缺陷基因的淘汰,正常的胚胎移植到母亲子宫内,确保出生正常的孩子。
28134篇文章 · 6381篇问答
#试管婴儿成功率
#试管婴儿成功率
试管婴儿的成功率包括妊娠率和活产率等。妊娠率是做手术后测出两条杠,证明已经怀孕的概率。它跟年龄有关,年轻女性妊娠率较高在45%,试管受孕成功后可以测出尿两条杠,并且B超能看到宫腔里有发育的孩子。活产率是指妊娠后能正常分娩胎儿的概率,因为部分人会出现胎停、流产现象。试管婴儿成功率与患者自身条件有关,比如:a、和年龄相关:年龄越小成功率越高,年龄越大成功率越低。随着年龄增长,试管婴儿成功率迅速下降,所以需要在年轻时尽快解决生育问题;b、和患者自身因素相关:如卵巢功能较差,或患有多囊卵巢综合征、维生素D缺乏、胰岛素抵抗的患者,其试管婴儿成功率也会下降;c、和生殖中心技术水平相关:其与试管婴儿成功率也有较大关系,若生殖中心水平较好,排除其他影响因素后,成功率在90%以上。
29940篇文章 · 7347篇问答
#鹤壁试管
#鹤壁试管
截止2023年初,鹤壁没有开展辅助生殖技术的医院,您可以去周边的城市:安阳(约40公里),濮阳(约66公里),新乡(约76公里)等城市。根据自己的需要选择合适的能做试管婴儿的医院。
50篇文章 · 9篇问答
